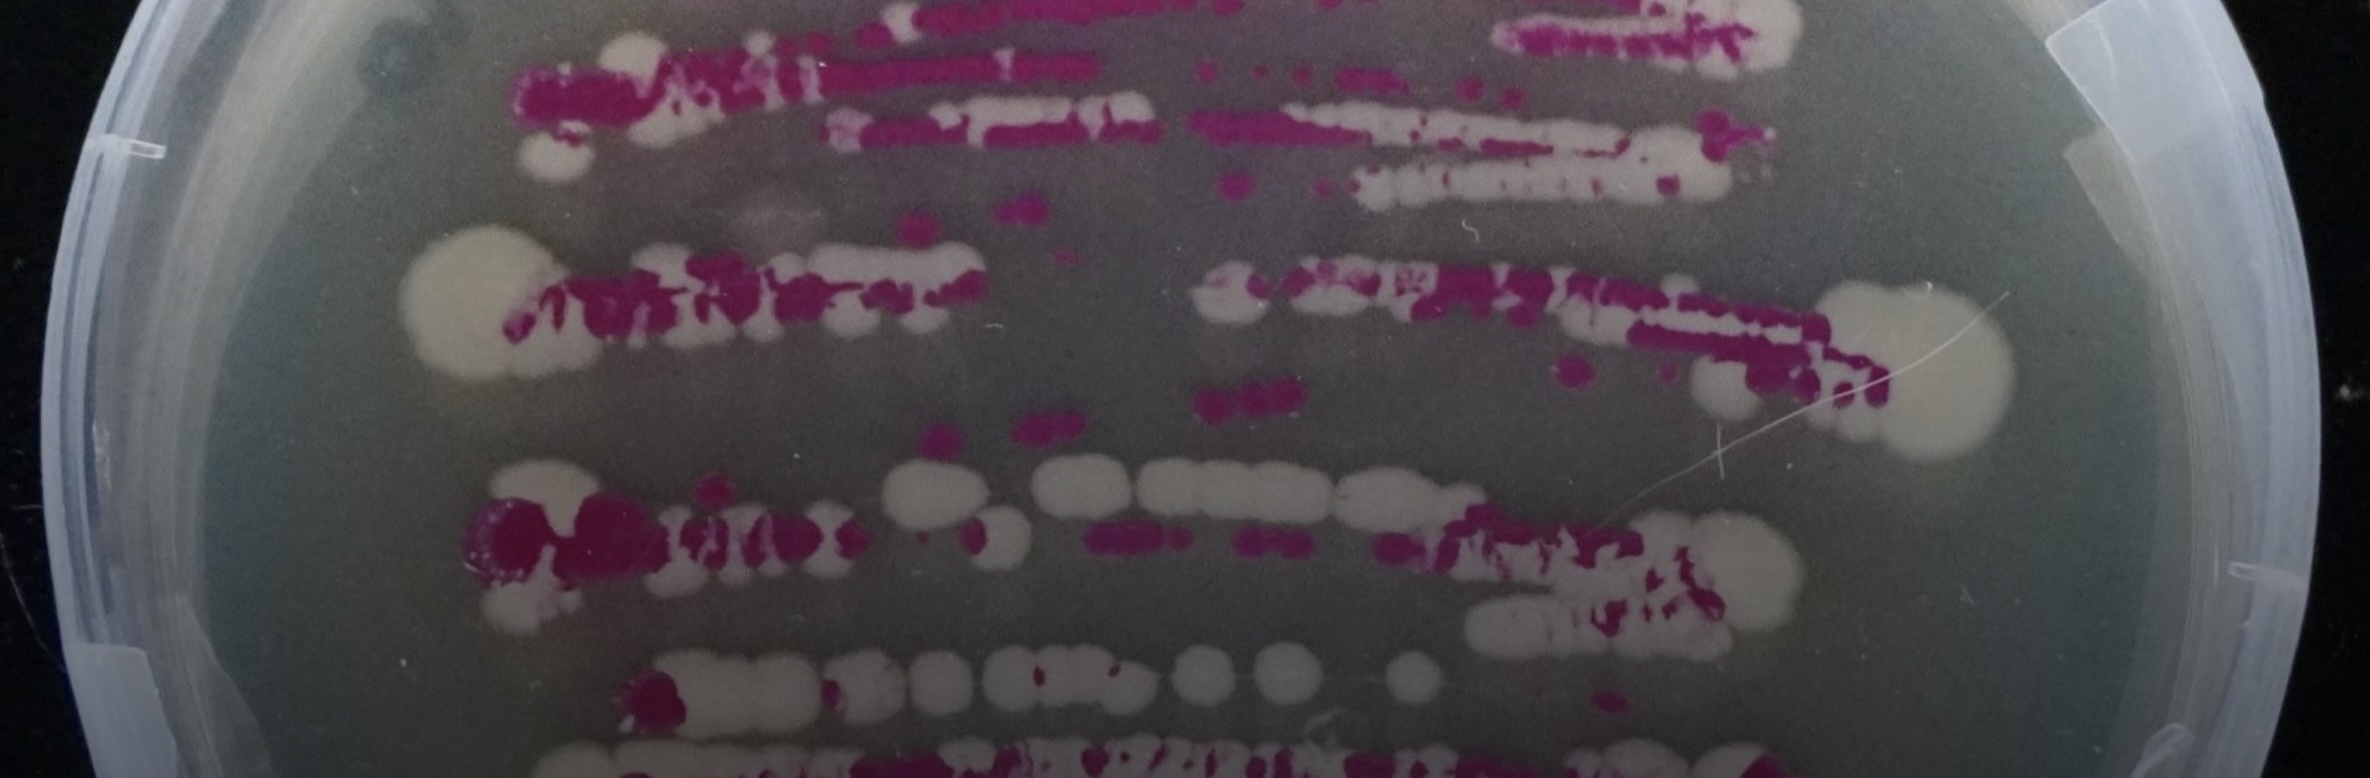
nasa-bacteria

4.12.2025
New research conducted on a NASA-discovered bacterium shows the microbe is capable of entering an extreme dormant state, essentially “playing dead” to survive in some of the cleanest environments on Earth.
The finding could potentially reshape how scientists think about microbial survival on spacecraft and the challenges of preventing contamination during missions to space. Preventing contamination matters because it helps keep space missions safe, while ensuring that any signs of life spotted elsewhere in the Solar System can be trusted.
“It shows that some microbes can enter ultra-low metabolic states that let them survive extremely austere environments, including clean rooms that naturally select for the hardiest organisms,” said Nils Averesch, Ph.D., an assistant professor in the University of Florida’s Department of Microbiology and Cell Science and a member of the Astraeus Space Institute.“The fact that this bacterium can intentionally suspend its metabolism makes survival on spacecraft surfaces or during deep-space cruise more plausible than previously assumed.”
In a recent report, scientists detailed the enigmatic Tersicoccus phoenicis, a rare type of bacteria found in the cleanest rooms where spacecraft are assembled and first discovered at NASA and European Space Agency facilities. This bacteria can remain inactive even when conditions improve, making it difficult to detect through standard sterilization checks. The organism does not form spores, a trait usually associated with extreme durability, which makes its resilience especially surprising.
“The fact that this bacterium can intentionally suspend its metabolism makes survival on spacecraft surfaces or during deep-space cruise more plausible than previously assumed.”—Nils Averesch
“What stood out most to me is that these microbes don’t form spores,” Averesch said. “Seeing a non-spore-former achieve comparable robustness through metabolic shutdown alone suggests there are additional, underappreciated survival mechanisms in bacteria that we haven’t fully characterized.”
Averesch emphasized that while the findings raise important questions for planetary protection, they do not necessarily mean Earth microbes could survive on planets like Mars. “Anything directly exposed on the Martian surface is unlikely to survive,” he said. “But in sheltered micro-niches — subsurface cracks, porous regolith or beneath rocks — dormant persistence becomes more plausible.”
A recent National Geographic article highlights more on this new finding.
Averesch is leading NASA-supported research at Kennedy Space Center exploring whether microbes can be used to biologically recycle plastic waste generated during long-duration space missions. The project is part of a statewide partnership that strengthens collaborations between UF and NASA to support the Moon-to-Mars program.
Quelle: University of Florida
